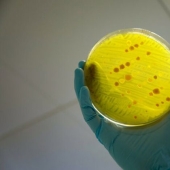
Quite disturbing facts about the world

Culture

13-01-2022
Seductive Parisian women in the paintings of French artist ...
Jean-Gabriel Domergue was born in Bordeaux, France, in 1889. Already at the age of 17, he exhibited his works at the Salon Des ...
13-01-2022
Quite disturbing facts about the world
We don't know much about the world. We often hear that people have explored only a small part of what is hidden in the ocean, and ...

13-01-2022
7 Facts About Makeup Artists That Prove Their Job Is Harder ...
In the film world, make-up artists are just as important as any other team, because thanks to them you can correctly reflect the ...

10-01-2022
Jack, is that you? American woman elevates cosplay to the ...
There is no such character in which the American Alison Tabbita (Alyson Tabbitha) could not be reincarnated. When Alison was a ...

10-01-2022
9 new travel bans that can make your life harder
Every year travel becomes more and more accessible: plane tickets are getting cheaper, as well as hotels and tours are getting ...

10-01-2022
10 largest churches in Russia
The dimensions of these Christian Orthodox churches are amazing. And some of them have been around for hundreds of years.

08-01-2022
Surreal illusions of South Korean artist Dain Yun
Continuing the theme of illusions, we bring to your attention a series of works by a talented South Korean artist Dain Yoon, who ...

06-01-2022
Digital portraits by Georgian artist Irakli Nadar
Irakli Nadar, 28, lives in Tbilisi. He creates incredible hyper-realistic digital portraits, the details and colors of which are so ...

03-01-2022
10 crazy rites of passage
Most cultures recognize the importance of rites. However, not all ceremonies are safe. Some can be completely fatal. The crazy ...

01-01-2022
"Make Love, not War": Stephen Maisel's most Controversial ...
Our post about Madonna's photobook "Sex" gives, we believe, a fairly complete idea of the skill of American photographer Steven ...

01-01-2022
5 secrets of ancient Egypt that we never knew about
For some of us, the pyramids of Egypt are no more than a tourist attraction. However, with scientific advances come exciting new ...

30-12-2021
"Goodbye, my friend, goodbye": 5 versions of Sergei Yesenin's ...
On December 28, 1925, the great Russian poet Sergei Alexandrovich Yesenin died. And his death became one of the most mysterious and ...

29-12-2021
9 Japanese traditions that are far beyond our comprehension
Japan is a unique country with old traditions that have been passed down from generation to generation. This country is able to be ...

28-12-2021
12 facts about Brazilian culture that make it so unique
Some people find it difficult to imagine an apartment without a carpet. But that's not the only amazing thing you'll find in ...

27-12-2021
"Love in female form" by Marina Tsvetaeva. What kind of ...
Marina Tsvetaeva has never been a prude. In addition to her beloved husband Sergei Efron, there was a place in her life for another ...

27-12-2021
15 shockingly realistic paintings
Patrick Kramer is an American hyperrealist artist from Springville, Utah. After graduating from Brigham Young University in 2008 ...

27-12-2021
10 facts about Cleopatra
One of the most famous and influential women in history, without a doubt, was Cleopatra, the last queen of Hellenistic Egypt. She ...

27-12-2021
Promotional posters showing Hong Kong dancers defying gravity
By the beginning of the new theatrical season, the Hong Kong Ballet has launched a driving, bright and stunning advertising ...

26-12-2021
13 weird and interesting facts about Christmas
Even though we are not celebrating Catholic Christmas, you will definitely want to hear some weird and interesting facts about ...

25-12-2021
Between art and fashion: photographs from the collection of ...
For more than 40 years, Carla Sozzani, a renowned Italian editor, publisher, and collector, has amassed one of the most important ...

23-12-2021
How Moscow was decorated for the New Year 2022
Every New Year, the Moscow authorities try to surpass the previous holiday season, transforming the city into a fabulous ...

22-12-2021
Was - became: how tattoos age
Are you thinking of getting a tattoo? Keep in mind: tattoos change over time, and sometimes dramatically. They fade, blur, fade ...

22-12-2021
Famous personalities through the eyes of the artist Dmitry Grozov
You have probably met the works of the Russian artist Dmitry «Ahriman» Grozov online. He draws various famous ...

22-12-2021
8 best islands in Croatia
When it comes to European islands, most people immediately think of famous and popular places like Ibiza and Santorini. However, ...

20-12-2021
How an artist combines reality with images from his smartphone
Israeli Yahav Draizin, an artist, father of three boys and deputy director of an advertising agency, creates art on the run. He ...

20-12-2021
8 interesting facts about Vietnam
Want to know more about Vietnam? Here are 25 interesting facts about Vietnam that you probably didn't know about before you read this.















